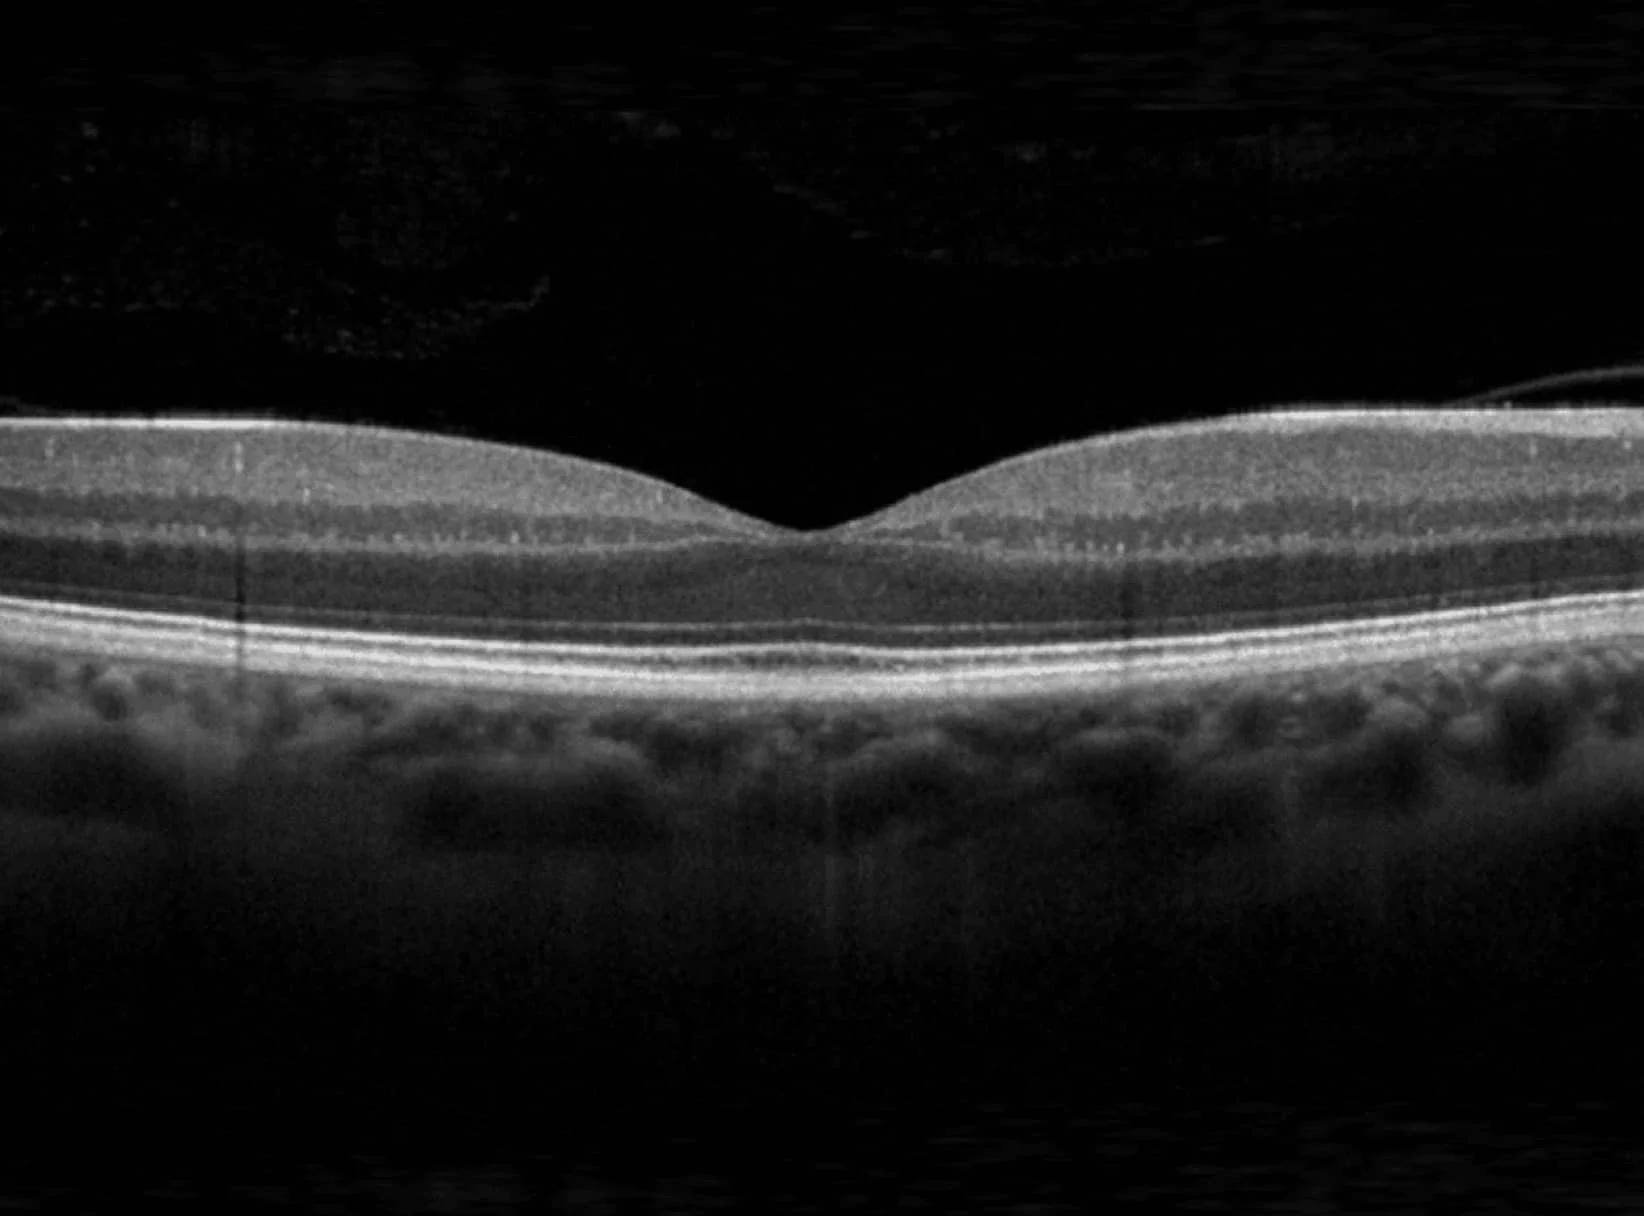

VISUAL FIELD TESTING, OCT AND RETINAL PHOTOGRAPHY
As well as our comprehensive eye exams, we provide visual field testing, OCT and retinal photography.

VISUAL FIELD TESTING
Visual field testing, also known as perimetry, measures how much of your visual field (peripheral vision) is intact. It's a crucial test for diagnosing and monitoring conditions like glaucoma, stroke, and multiple sclerosis as well as assessing fitness to drive.
OPTICAL COHERENCE TOMOGRAPHY
Optical Coherence Tomography (OCT) represents cutting-edge diagnostic imaging that employs light wave technology to generate detailed cross-sectional views of ocular tissues. This sophisticated technique captures microscopic details of retinal and anterior eye structures with precision comparable to ultrasound but with superior resolution. Eye care specialists rely on OCT to identify early signs of conditions like glaucoma, macular degeneration, and diabetic eye disease—often detecting problems before patients notice symptoms. The examination is comfortable, rapid, and non-contact, establishing OCT as a cornerstone of contemporary eye care practice. By enabling precise diagnosis and tailored treatment strategies, this revolutionary technology has transformed ophthalmology, offering the potential to preserve vision through earlier detection and intervention than previously possible.

RETINAL PHOTOGRAPHY
Retinal photography, also known as fundus photography, is a technique used to capture detailed, high-resolution images of the back of the eye, specifically the retina, optic nerve, and blood vessels. This process helps us diagnose and monitor various eye conditions and assess overall eye health.
BOOK YOUR EYE EXAM TODAY!
At our Adelaide CBD practice near Rundle Mall, we specialize in visual field testing, OCT, and retinal photography. Your eye health is our top priority, and we take the time to get to know you, answer your questions, and address any concerns with care.

WHY CHOOSE
DESIGN EYEWEAR
Design Eyewear is an independently owned boutique optometry practice in the Adelaide CBD specialising in distinctive frame lines. We don’t just want to sell people glasses, we want to find the frame that expresses their unique style and personality.
We bring an unparalleled eyewear experience to our patients through distinctive frame lines, the highest innovation of lenses and superb personal service that exceeds expectations.

